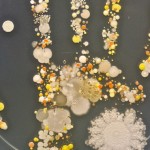

Los siguiente consejos son patrocinados por Tide® and Gain® & Latina Bloggers Connect y son en base a mis experiencias personales. El artículo no fue editado por terceros
Vivir en una ciudad en donde más del 90% del año hace calor, tiene un inconveniente: nos cambiamos de ropa varias veces al día para mantenernos frescos. Y al día pueden ser 4 o 5 cambios de ropa solo de mi parte, así que se imaginarán lo que tengo que lavar luego de 3 o 4 días.
Y yo que pensaba que una vez que mis hijas dejarán atrás sus etapas de bebés y toddlers, todo iba a ser lavar 3 prendas, y reír y cantar! Que inocente…
Así que entre mi trabajo online, el trabajo de la casa, niñas, marido y una respetable cantidad de etcéteras, en lo que menos quiero perder tiempo, es en el lavado de la ropa.
Y con esa idea en mente, descubrí que puedo apoyarme en los Gain Flings, que reducen sustancialmente el tiempo que le dedicaba a revisar la ropa limpia y checar que las manchas habían desaparecido.

Pero que son Gain Flings?
Son pequeños packs que se dividen en tres compartimentos que te brindan una triple experiencia: detergente, el poder limpiador de OxiBboost, y el poder de Febreze para remover el mal olor, todo en un pack premedido.
Los Gain Flings contienen una formula concentrada con dos veces más ingredientes limpiadores que el detergente líquido, y han sido diseñados para que funcionen bajo todo tipo de condiciones de lavado, y que sean seguros tanto para la ropa blanca como para la de color.
Y funcionan en cualquier tipo de lavadora! lo que hace que nadie se quede con las ganas de probar por si misma este auxiliar increíble.
Y su uso no podía ser más simple!: se coloca un pack en la lavadora y luego se echa la ropa. Si, así de fácil, porque como ya te conté, los packs viene premedidos con la cantidad precisa de detergente, para evitar que se desperdicie o se derramen, y para brindar resultados consistentes en cada lavada.
Ves? no solo son fáciles de usar, el aroma que dejan en tu ropa es sencillamente i-rre-sis-ti-ble!!!!
Importante: por muy adorable que se vean tus Gain Flings, siempre siempre, debes guardarlos fuera del alcance de tus hijos. De preferencia, en una superficie elevada a la cual no tengan acceso posible.
¿Te convencí y quieres saber más? Visita la web de Gain Pacs y empieza a disfrutar de esta manera de simplificar tu vida. Y en Twitter, la cuenta de Gain Latino está actualizada permanente con sus últimas novedades.
Sorteo!
Una afortunada residente de Estados Unidos se puede hacer acreedora de una cubeta de Tide pacs y una cubeta de Gain Flings. solo debes ser mayor de 18 años y participar a través del siguiente formulario:
L aganadora será contactada vía email, teniendo 48 hs para responder. Caso contrario, se procederá a elegir una nueva ganadora.
Suerte!!!
–
This is a sponsored conversation written by me on behalf of Tide® and Gain® and Latina Bloggers Connect. However all opinions expressed are my own.

7 Comments
Anahi
16 junio, 2015quiero la cubeta! 😉
Valentina F
16 junio, 2015Me encanta gain, yo siempre lo uso para lavar toda la ropa de mi fam. Y la deja limpia y con un olor a limpio.
Mayito Castillo
16 junio, 2015Los miembros de mi familia que hacen que la lavadora trabaje mucho mas, son mis dos nietos! Gracias por el sorteo!
Mayela
16 junio, 2015Pobre de mi lavadora pero mi esposo es el q la hace trabajar mas!
Lupita
16 junio, 2015mis hijos son los que asen trabar mas mi lavadora
Gracias por el sorteo
betty
16 junio, 2015soy la unica que la usa , asi que yo la hago trabajar mas !
Maria Beas
16 junio, 2015Si duda mi esposo, a cada rato quiere lavar su ropa y siempre termina con mi detergente de ropa le vasea casi media botella cuando es liquido y cuando es en polvo le pone hasta seis tazas. Cuando es gain flings usa seis o siete para una sola lavada 🙂 me deja sin detergente mi Sr. esposo y por eso ahora solo lo estoy cuidando.